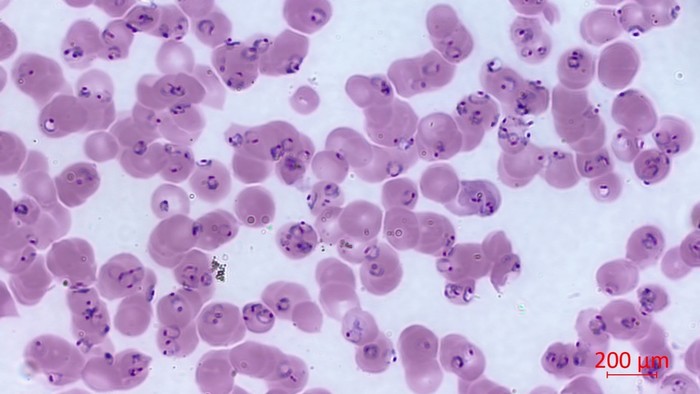

26.04.2023
Specjaliści z Instytutu Medycyny Morskiej i Tropikalnej GUMed w Gdyni na czele z dr. hab. Maciejem Grzybkiem, prof. uczelni z Zakładu Parazytologii Tropikalnej zorganizowali 25 kwietnia 2023 r. konferencję z okazji przypadającego tego dnia Światowego Dnia Malarii ustanowionego przez WHO. W wydarzeniu wzięli udział m.in.: prorektor ds. studenckich GUMed dr hab. Tomasz Smiatacz, dziekan Wydziału Nauk o Zdrowiu z IMMiT prof. Przemysław Rutkowski, dyrektor Uniwersyteckiego Centrum Medycyny Morskiej i Tropikalnej prof. Marcin Renke oraz powiatowy inspektor sanitarny w Gdyni lek. Tomasz Kiliński.
– Spotykamy się dzisiaj w IMMiT, aby podnieść świadomość pracowników systemu ochrony zdrowia, pacjentów, podróżników, a także osób, które wybierają się za granicę, aby w sposób bezpieczny mogli spędzać czas za granicą i żeby wrócili w pełnym zdrowiu do domów. Malaria powoduje rocznie ponad 240 mln zarażeń i kończy się to około 600 tys. zgonów w skali świata, dlatego warto o niej mówić – podkreślał dr hab. Maciej Grzybek, prof. uczelni przed oficjalnym otwarciem obrad.
Jak wskazywał Profesor, warto mówić o najnowszych metodach diagnostycznych i epidemiologii malarii, aby umożliwić pacjentom, wyjeżdżającym do krajów tropikalnych oraz przygotowującym ich do tego personelowi lekarskiemu dostęp do najnowszej wiedzy z zakresu przeciwdziałania zachorowaniu na to schorzenie.

Konferencję otworzył prorektor dr hab. Tomasz Smiatacz.
– Malaria nadal stanowi wyzwanie. Mamy leki przeciwmalaryczne i duże możliwości oddziaływania środowiskowego, pojawiła się szczepionka. Nadal jesteśmy daleko od celu, jednak myślę, że będzie się dokonywał postęp w tej kwestii. Jest to szczególnie istotne, ponieważ wielu z nas znów zaczęło podróżować i narażać się na zachorowanie – podkreślał prorektor dr hab. Tomasz Smiatacz, kierownik Kliniki Chorób Zakaźnych GUMed.
Głos zabrał także dziekan Wydziału prof. Przemysław Rutkowski.
– Bardzo się cieszę, że mogę tu być. Gratuluję Państwu tego, że spotykacie się Państwo tutaj już po raz drugi i omawiacie zagadnienia prewencji i diagnostyki malarii – mówił dziekan prof. Przemysław Rutkowski. – Mam nadzieję, że obrady będą owocne i umożliwią wyciągnięcie wniosków, które pozwolą w przyszłości podjąć dalsze działanie związane z tymi zagadnieniami.
Wykład inauguracyjny wygłosiła prof. Katarzyna Sikorska, p.o. kierownika IMMiT, która omówiła występowanie malarii w Polsce w ostatnich latach, podkreślając, że choć pandemia COVID-19 spowodowała czasowe zmniejszenie liczby przypadków tej choroby w naszym kraju, w ostatnich latach obserwuje się jej wzrost do wartości sprzed 2020 r. W kolejnym wystąpieniu dr Agnieszka Wroczyńska z UCMMiT wyjaśniła zasady przygotowania do podróży do krajów, gdzie choroba ta występuje powszechnie.
Podczas wykładów zamykających konferencję dr Anna Kuna z Kliniki Chorób Tropikalnych i Pasożytniczych przybliżyła tematykę aktualnych wytycznych profilaktyki malarii, natomiast dr hab. Beata Szostakowska z Zakładu Parazytologii Tropikalnej omówiła zagadnienia związane z diagnostyką tego schorzenia.
Malaria jest chorobą wektorową, którą wywołuje pierwotniak z rodzaju Plasmodium. Jest ona przenoszona przez samice komara z rodzaju Anopheles i stanowi istotne zagrożenie dla zdrowia publicznego, zwłaszcza w krajach o niskim i średnim dochodzie. Za rozwój zimnicy odpowiedzialnych jest 5 gatunków Plasmodium: P. falciparum, P. vivax, P. malariae, P. ovale i P. knowlesi. P. falciparum jest najbardziej niebezpiecznym gatunkiem i jest odpowiedzialny za większość przypadków ciężkiej i śmiertelnej malarii.
Do zarażenia zarodźcem malarii w większości przypadków dochodzi poprzez ukłucie komara. Istnieją również inne drogi zarażenia, takie jak wędrówka pasożyta z krwią matki do ciała płodu (via placenta), czy poprzez kontakt z krwią zarażonego (np. poprzez zakłucie igłą podczas zabiegów pielęgniarskich). W latach 2021-2022 na zimnicę zachorowało 488 mln ludzi, co spowodowało ponad 1,24 mln zgonów w skali świata.
Badanie cienkiego rozmazu krwi umożliwia potwierdzenie zarażenia, ocenę liczby zarażonych czerwonych krwinek (poziom parazytemii), rozpoznanie gatunku i formy rozwojowej pasożyta. Na zdjęciu widoczne liczne młode trofozoity (pierścionki) P. falciparum w czerwonych krwinkach. Bardzo wysoka parazytemia świadczy o poważnym stanie pacjenta.
fot. dr hab. Maciej Grzybek, prof. uczelni
Krajowy Ośrodek Medycyny Tropikalnej IMMiT prowadzi kompleksową diagnostykę malarii u pacjentów powracających ze strefy tropikalnej. Laboratorium diagnostyczne Zakładu Parazytologii Tropikalnej wykorzystuje badania podstawowe – cienki rozmaz krwi i badanie grubej kropli krwi jako złoty standard diagnostyczny, oraz badania molekularne z wykorzystaniem łańcuchowej reakcji polimerazy. Pracownicy Zakładu organizują szkolenia i kursy doskonalące dla diagnostów laboratoryjnych celem poprawienia jakości i skuteczności diagnostyki malarii i innych chorób tropikalnych i pasożytniczych.
fot. Paweł Sudara/GUMed